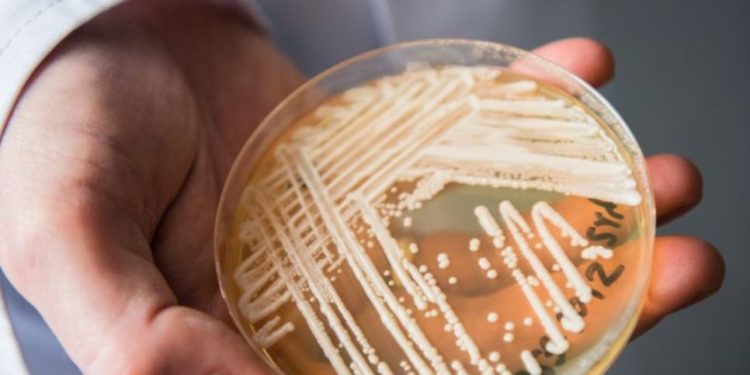
Një kërpudhë vrasëse alarmon spitalet/ Ja vendi më i prekur

Një kërpudhë vrasëse po përhapet gjithnjë e më shumë në spitalet evropiane dhe Italia është ndër vendet më të prekura. Ajo quhet ”candidozyma auris” dhe ka shkaktuar mbi 4 000 raste në vendet e Bashkimit Evropian midis viteve 2013 dhe 2023.
Alarmi u ngrit nga ECDC, Qendra Evropiane për Parandalimin dhe Kontrollin e Sëmundjeve, e cila, bazuar në një studim të 36 vendeve, vuri në dukje një përhapje të shpejtë dhe një kulm të rasteve në vitin 2023 (1 346).
Italia u rendit e treta për sa i përket rasteve të raportuara (712), pas vetëm Spanjës (1 807 raste) dhe Greqisë (852). Alarmi është përhapur vetëm në pak vite, duke kaluar nga raste të izoluara në shpërndarje të gjerë në disa vende.
“Pavarësisht rritjes së numrit të rasteve, vetëm 17 nga 36 vende aktualisht kanë një sistem mbikëqyrjeje kombëtare. Shkalla e vërtetë e problemit ka të ngjarë të jetë nënvlerësuar”, theksojnë studiuesit.
Shpërthimet e fundit janë raportuar në Qipro, Francë dhe Gjermani, ndërsa Greqia, Italia, Rumania dhe Spanja kanë deklaruar se nuk janë më në gjendje të dallojnë shpërthime specifike për shkak të përhapjes së gjerë rajonale ose kombëtare.